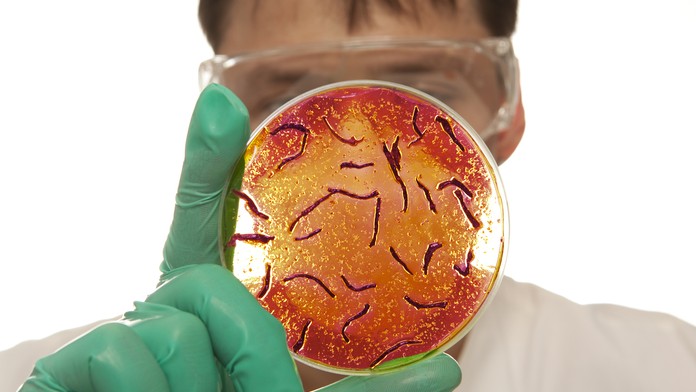
Cholera- ilustračná snímka.

V Iraku vypukla epidémia cholery. Ochorelo vyše 1800 ľudí, šesť zomrelo
Prvé prípady objavili minulý mesiac západne od Bagdadu.
Irak bojuje s prvou epidémiou cholery od roku 2012. Nakazilo sa ňou vyše 1800 ľudí a šiesti na ňu už zomreli, informoval dnes hovorca irackého ministerstva zdravotníctva. Podľa jeho slov sa epidémia rozšírila aj do severoirackého Kurdistanu.
Ochorenie môže počas niekoľkých hodín vyústiť do smrti pacienta v dôsledku dehydratácie a zlyhania obličiek, ak zostane neliečené. Prvé prípady objavili minulý mesiac západne od Bagdadu.
Väčšina nových prípadov sa vyskytla práve tam a v provincii Bábil južne od Bagdadu, povedal agentúre Reuters v telefonáte hovorca ministerstva Ahmad Rudajní. Hovorca kurdského ministerstva zdravotníctva potvrdil dva prípady cholery v Arbíle a dva ďalšie v Dahúku, podľa jeho slov v Kurdistane zatiaľ nik na choleru nezomrel.
Ministerstvo zdravotníctva si vysvetľuje epidémiu cholery nízkou hladinou vody v rieke Eufrat, z ktorej si miestni obyvatelia berú vodu na pitie či poľnohospodárske využitie, a tiež zimnými záplavami, ktoré rieku znečistili. Kontaminovať ju mohli aj plytké jamy s odpadovou vodou, uviedol Reuters.
Sledujte Televízne noviny vo full HD a bez reklám na Voyo





























